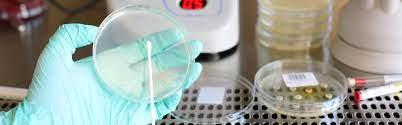
The pyrogen testing market was valued at USD 624.2 million in 2016 and is predicted to grow at a CAGR of 9.8 percent to USD 1659.04 by 2030. pyrogen testing market

The pyrogen testing market was valued at USD 624.2 million in 2016 and is predicted to grow at a CAGR of 9.8 percent to USD 1659.04 by 2030.
Pyrogen testing are used in pharmaceutical business to check the presence of pyrogen contamination. Pyrogen testing is essential in order to avoid infections that can be spread by both non-microbial and microbial sources. Various methods and tests have been developed in recent years to provide solutions for testing pyrogens and endotoxins.
Pharmaceutical, biotech, and other drug manufacturing companies utilise pyrogen testing to ensure that their products are safe to manufacture and release into the market. Increased pharmaceutical and biotech companies, increased demand for pharmaceutical products, and strict government restrictions surrounding drug safety are the main drivers driving the market.
However, strong government control of the exam, a lack of in-depth knowledge of the tests, and an expanding revolution in existing technologies could provide a challenge to this sector.
The pyrogen testing market is divided into four categories: product, test type, application, and end-user. Instruments, services, kits, and reagents are the product segments of the pyrogen testing market. Recombinant factor C assay (rFC), limulus amoebocyte lysate (LAL) test, monocyte activation test (MAT), and rabbit pyrogen test are the several types of tests available (RPT). The market is divided into three categories based on application: pharmaceuticals and biologics, medical devices, and other application systems. The market is divided into medical device companies, pharmaceutical businesses, biotechnology companies, and food and beverage companies based on end-user.
The global pyrogen testing market is divided into four regions: the Americas, Europe, Asia-Pacific, and the Middle East and Africa. The Americas are divided into two sections: North America and South America. The United States and Canada make up the North American region. Western Europe and Eastern Europe are the two halves of the European continent.
